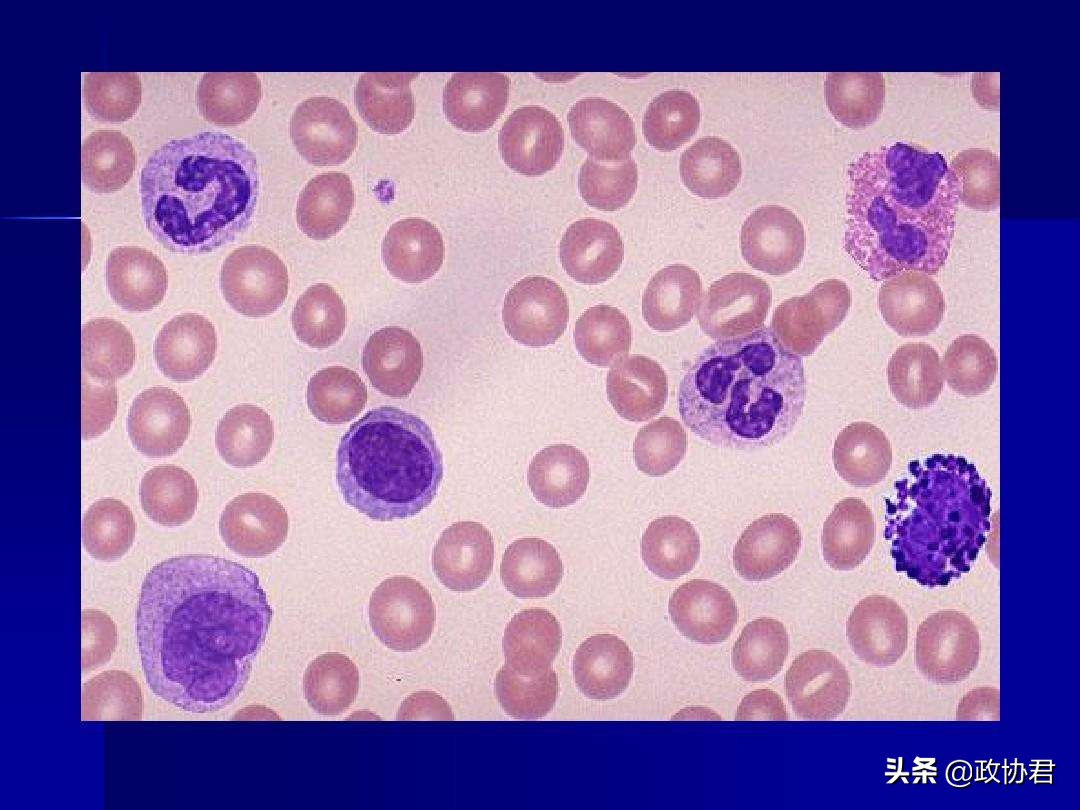
慢粒白血病靶向药伊马替尼,白血病新药的研发

“耐立克是中国第一个、也是目前唯一一个第三代BCR-ABL*制剂抑**,能有效地解决中国耐药慢粒白血病患者无药可医这一重大社会问题,填补了临床急需产品的国内空白。作为国家重大专项支持的新药,耐立克代表了我国原创新药的实力,是重大专项实施的亮点和骄傲;耐立克的上市也充分彰显了中国本土医药的创新水平,将激励更多医药企业投身创新药研发,不断提升中国医药研发创新能力,助力‘健康中国2030’目标的实现。”12月18日,在由中国医药创新促进会主办的国家“重大新药创制”专项成果发布暨奥雷巴替尼(商品名:耐立克)全球首发上市会上,十二届全国政协委员、重大新药创制国家重大科技专项技术副总师陈凯先院士这样表达心声。
多位参与了耐立克上市前临床试验的患者,也在发布会上表达了自己的激动。
“几年前,在被医生宣布我出现了耐药现象之后,我就知道自己的人生不久将要画上句号。但因为有幸参加了临床试验,我到现在还活着,这几年都是赚来的。”
“作为一名年近40的独生子,我死不起。新药耐立克上市,让我不再是无药可医,我也不再惧怕离开这个问题。”
“真的很感动,我们这些已经陷入绝望的患者,因为耐立克又重新燃起了生的希望。”
……
耐立克,是亚盛医药全资子公司广州顺健生物医药科技有限公司研发的一款新药。该药于11月25日,获得中国国家药品监督管理局(NMPA)的上市批准,用于治疗任何酪氨酸激酶*制剂抑**(TKI)耐药,并采用经充分验证的检测方法诊断为伴有T315I突变的慢性髓细胞白血病(CML)慢性期(CP)或加速期(AP)的成年患者。
很多人对CML的认识,来源于电影《我不是药神》,这是一种与白细胞有关的恶性肿瘤。随着靶向BCR-ABL的酪氨酸激酶*制剂抑**(TKI)的问世,CML的治疗方式得以革新。如今,CML已由曾经的不治之症转变为像高血压、糖尿病一样的“特殊慢病”。尽管如此,获得性耐药一直是CML治疗的主要挑战,仍有部分患者因耐药导致疾病进展甚至死亡。BCR-ABL激酶区突变是获得性耐药的重要机制之一,其中T315I突变是常见的耐药突变类型之一,在耐药CML中的发生率高达25%左右。伴有T315I突变的耐药CML患者对目前所有一代、二代BCR-ABL*制剂抑**均耐药。在耐立克获批上市前,中国携T315I突变耐药CML患者长期面临着无药可医的窘境。
“因此,耐立克的上市,对临床医生和患者来说都意义巨大。因为,过往临床研究的有效性和安全性数据不断向我们显示,作为打破了因为中国CML治疗原有耐药困境的全新里程碑药物,耐立克极有希望成为该领域治疗的‘Best-in-Class’(最佳)药物。”耐立克中国临床试验主要研究者、北京大学血液病研究所所长、北京大学人民医院血液科主任黄晓军教授介绍。
亚盛医药董事长、CEO杨大俊博士则进一步表示,耐立克作为填补国内空白、临床上不可或缺的急需产品,其上市可以让电影《我不是药神》里的社会之痛不再发生。
记者在发布会上同时获悉,作为中国CML领域第一个根据基因突变状态选择治疗的获批药物,耐立克的上市开启了CML精准化治疗和商业化进程的全新篇章。据亚盛医药首席商务运营官祝刚介绍,目前耐立克在全国各地的首批处方已经陆续开出。“我们正在积极推进耐立克在全国的落地。我们也将在商业化合作方面持续发力,期待与更多合作伙伴携手商业创新,打开多维度合作的大门,共同推进耐立克获批上市后的商业化进程,让全国更广泛地区的患者都能用得上创新药物。”祝刚说。
实际上,不只是中国的省份和地区,耐立克的上市,也有望在全世界范围内惠及其他国家的患者。
“在耐立克的研发过程中,我们始终坚持国际标准且技术领先全球,是全球范围内第二个进入美国临床的第三代BCR-ABL*制剂抑**,也是为数不多自立项开始就执行全球研发策略的中国本土原创新药。基于耐立克优异的临床有效性及安全性,其先后获得美国FDA的孤儿药资格认定和快速审评资格认定。此外,耐立克相关研究自2018年起连续4年入选全球知名血液病年会美国ASH年会的口头报告,并获2019年度ASH最佳研究提名奖,要知道这在国内是非常少见的,这一切充分显示了国际血液学界对耐立克的高度认可。希望在不远的将来,耐立克这一中国原创、全球领先的创新药能惠及更多的全球患者。”亚盛医药首席医学官、顺健医药总裁兼首席执行官翟一帆博士最后介绍。
原文刊登于2021年12月22日《人民政协报》第6版健康周刊
记者:刘喜梅